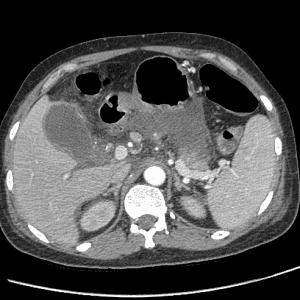
Viêm tụy cấp

TIÊU HOÁ
Hiển thị 601–620 của 1445 kết quảĐã sắp xếp theo mới nhất
-

FNH
Lượt xem: 181» 18-10-2020 -

FNH
Lượt xem: 275» 18-10-2020 -

Nang sán
Lượt xem: 153» 17-10-2020 -

Nang sán
Lượt xem: 137» 17-10-2020 -

U nhầy ruột thừa
Lượt xem: 313» 14-10-2020 -

Nang giả tụy
Lượt xem: 141» 14-10-2020 -

U tụy
Lượt xem: 128» 12-10-2020 -

U dạ dày
Lượt xem: 169» 12-10-2020 -

Chấn thương gan
Lượt xem: 154» 12-10-2020 -

Chấn thương gan
Lượt xem: 135» 12-10-2020 -

U tụy
Lượt xem: 134» 12-10-2020 -

Co thắt tâm vị
Lượt xem: 157» 08-10-2020 -

Túi thừa thực quản
Lượt xem: 153» 03-10-2020 -

Thủng ruột
Lượt xem: 316» 30-09-2020 -

Xoắn dạ dày
Lượt xem: 230» 30-09-2020 -

Viêm túi thừa đại tràng
Lượt xem: 196» 30-09-2020 -

Viêm tụy cấp
Lượt xem: 597» 28-09-2020 -

Lồng ruột
Lượt xem: 222» 25-09-2020 -

GIST dạ dày
Lượt xem: 301» 25-09-2020 -

Chấn thương cơ hoành
Lượt xem: 173» 15-09-2020